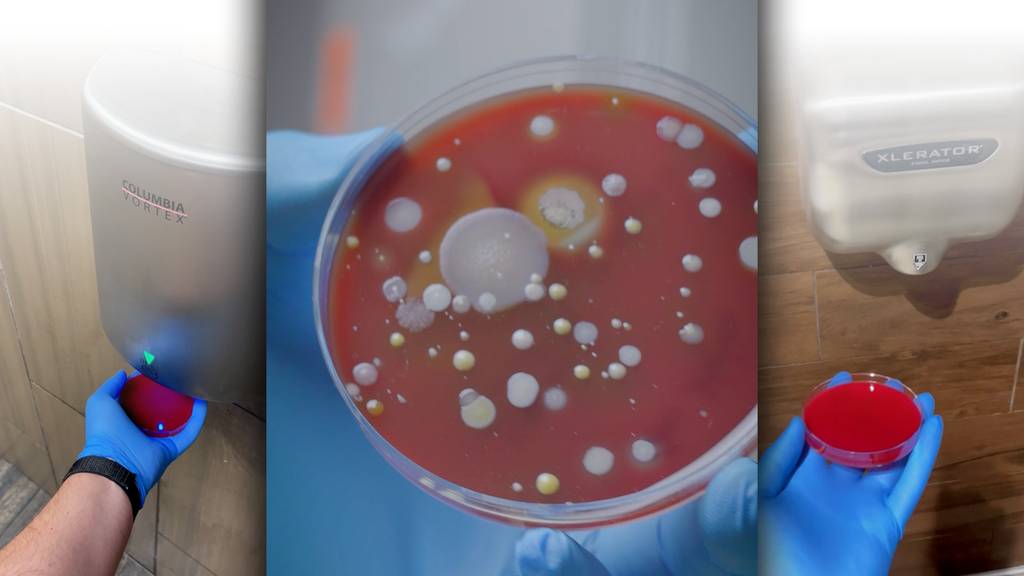

domingo-alvarez-e-Cs3y8Mn6-Gk-unsplash
Foto: unsplash.com
Quiz
Das bedeuten die Emojis wirklich!
Wir brauchen sie jeden Tag, ein Leben ohne sie wäre fast nicht mehr vorstellbar: Die Rede ist von den Emojis.
Wer schreibt heute noch eine Nachricht ohne die zwinkernden Smileys und bunten Symbole? Wir drücken uns mit ihnen aus, manchmal mehr als mit Worten. Doch oftmals setzen wir sie völlig falsch ein. Weisst du, was all die Symbole wirklich bedeuten?
Teste es jetzt in unserem Emoji Quiz: